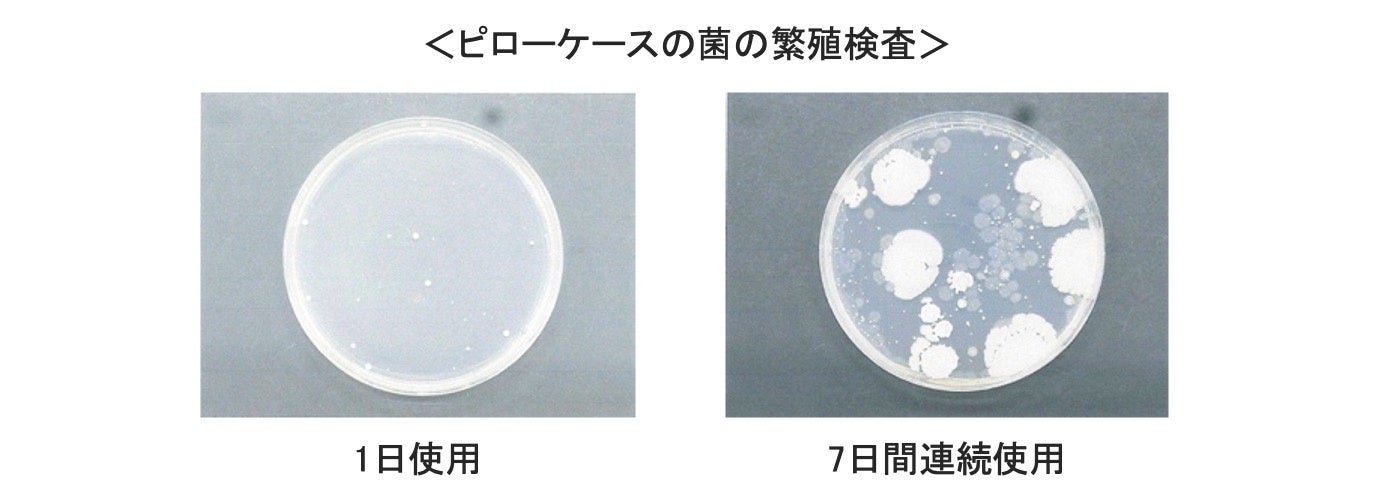

寝具なのに化粧品!西川の美容睡眠ブランド「newmine」から、肌や髪にうるおいを与える寝具『ニューミン コスメティックス シリーズ』が新登場
ビタミンE(※1)を放出して保湿ケア(※2)するピローケースなどを8月下旬から発売

西川の美容睡眠ブランド「newmine」は、“美しさは、夜のあいだに。”をコンセプトに、美しさを育てる時間としてバスタイムからリラックスタイム、就寝までの夜間美容ルーティンを提案し、肌や髪へのダメージを最小限に抑え、同時に至福の使用感で五感をゆるめて快適な入眠へ誘う多彩なアイテムを展開します。
就寝中は美肌・美髪が生まれ変わる大切な時間です。新登場する「ニューミン コスメティックス シリーズ」は、美容液やナイトクリームの代わりに、睡眠中のうるおいケア(※2)を叶える美容液成分配合の寝具です。肌や髪が直接触れるピローケース、フェイスラインカバー、掛けふとんカバーを展開します。保湿効果の仕組みは特別な生地にあります。繊維内に美容液成分として知られるビタミンE(※1)を貯蔵し、肌が触れるとビタミンE(※1)が放出して肌(角層まで)に浸透。寝ている間に、手軽かつ効果的に乾燥や肌あれを防いで肌を健やかに保ちます。この保湿効果は、布製品でありながら医薬品医療機器等法による「化粧品」として届出をしています。また、ビタミンE(※1)は直接繊維に練り込んでいるので、洗濯しても成分がすぐになくなるわけではありません。
明日の目覚めに、みずみずしいうるおいを。寝具で簡単にスキンケアできる「ニューミン コスメティックス シリーズ」をぜひお試しください。
※1 酢酸トコフェロール(うるおい成分)
※2 肌や髪に触れた部分のみ

新商品「 newmine cosmetics series 」概要
忙しい毎日に、寝具でお肌のうるおいケア
【特長】
■ 寝ている間に肌や髪へうるおい(※2)を与える保湿効果
繊維にうるおい成分のビタミンE(※1)を練り込んだ生地を採用。睡眠中にお肌が触れて体温や摩擦に反応することで、生地がビタミンE(※1)を放出し、皮膚(角層まで)が吸収するという仕組みです。睡眠中に手軽かつ効率的に肌を健やかに保ちます。

■ 洗濯機でお手入れ可能、洗濯しても保湿効果は継続
ご家庭の洗濯機でお手入れ可能。ビタミンE(※1)は繊維に直接練り込んでいることから、洗濯しても成分がすぐになくなるわけではありません。
■ 寝具なのに化粧品としての効果が期待できる
『ニューミン コスメティックス シリーズ』の保湿効果は、布製品でありながら医薬品医療機器等法による「化粧品」として届出されています。

【newmine cosmetics series 展開アイテム】
○ newmine ピローケース ※化粧品
寝ている間に肌や髪へうるおいを与える(※2)ピローケース。
税込価格:6,600円
組成:綿65%、レーヨン20%、再生繊維(セルロース)15%
サイズ:90×45cm
カラー:ホワイト、グレー
newmine ピローケース ※化粧品
○ newmine フェイスラインカバー ※化粧品
顔が触れる掛けふとんのえり部分にかぶせて、肌を保湿ケア(※2)する部分カバー。
税込価格:11,000円
組成:綿65%、レーヨン20%、再生繊維(セルロース)15%
サイズ:150×50cm
カラー:ホワイト、グレー
newmine フェイスラインカバー ※化粧品

○ newmine 掛け布団カバー ※化粧品
体が触れる裏面にビタミンE(※1)を練りこんだ生地を使用し、睡眠中にうるおいリペア。
税込価格:27,500円
組成:表/綿100% 裏/綿65%、レーヨン20%、再生繊維(セルロース)15%
サイズ:150×210cm
カラー:ホワイト、グレー
newmine 掛け布団カバー ※化粧品
※1 酢酸トコフェロール(うるおい成分)
※2 肌や髪に触れた部分のみ
その他の「newmine」おすすめ新商品
【肌に近い天然繊維 シルクのおふとん】
シルクは、アミノ酸を含むフィブロインとセリシンのタンパク質から成り、人の肌と近い構成でできています。繊維が細くしなやかなので、肌ざわりもやわらかく、ずっと触れていたくなるようなやさしさに満ちた繊維です。
また、シルクの吸湿率は、綿と比べて約1.2倍(※3)。ポリエステルと比べると約38倍(※3) 。余分な湿気を吸って吐く吸放湿性に優れているので、ムレ感を軽減し快適な状態を保つ繊維です。

○ 洗えるシルクのおふとん
季節の変わり目の気象の変化にも対応できる、あると嬉しい1枚です。
税込価格:110,000円
組成:ふとんがわ / シルク100% 、詰め物 / シルク100%
サイズ:150×210cm
カラー:アイボリー、シルバー
洗えるシルクのおふとん
※3 シルク、綿、ポリエステルのわたを比較。西川株式会社調べ。
【天然由来成分のCICA(ツボクサエキス)加工のブランケット】
セリ科の植物、ツボクサから抽出されるエキス=CICAによる柔軟加工を施すことで、生地のやわらかさを引き立てます。お休み前に、心地よい風合いのブランケットに包まれてリラックスタイムを。

○ ニューミンリラックス ブランケット(CICA加工)
シープボア調のふわふわもこもこタッチのブランケット。
税込価格:4,950円
組成:ポリエステル100%
サイズ:140×200cm
カラー:アイボリー、ベージュ
ニューミンリラックス ブランケット(CICA加工)
これもおすすめ!「newmine」人気商品
【タオルドライ時のダメージを抑える髪にやさしいタオル】
吸水性の高い「パフィールコットン」を使用し、毛流れに合わせた特許構造で、ゴシゴシこすらずに水分をしっかり吸収するのでキューティクルが傷つきにくく、素早く乾かすことができます。一般的なタオルと比較して、髪への摩擦係数を約12%軽減(※4)、ドライヤー時間を約30%短縮(※5)して髪のダメージを抑えます。

○ 髪にやさしいタオル(クイックブロー)
髪の長さに合わせた3サイズ展開。 表裏で使い分けができます。
税込価格:ショートヘアー用1,760円、セミロングヘアー用2,200円、ロングヘアー用2,970円
組成:綿100%
サイズ:ショートヘアー用34×70cm、セミロングヘアー用34×90cm、ロングヘアー用34×120cm
カラー:グレー、レッド、ホワイト
髪にやさしいタオル(クイックブロー)
※4 newmine 髪にやさしいタオルと当社従来品タオル(綿100%)の比較。予備洗浄、ダメージ処理を行った毛束を水道水に2分間浸した後、タオルに挟み込み、横方向の摩擦を20往復加えた後に、電子顕微鏡による毛髪表面撮影(X500)。西川株式会社調べ。
※5 当社従来品タオル(綿100%、日本製)と比較。西川株式会社調べ。
睡眠と美の深い関係
日本睡眠科学研究所の共同研究結果
睡眠を改善すると、免疫力アップや生活習慣病予防など、さまざまな面で身体に影響を及ぼす可能性があることが証明されてきました。美容においても、睡眠時間が不足すると肌が荒れやすくなることは確かです。では、単純に睡眠時間を延ばせばよいのか?きれいになるために、忙しい毎日のなかで頑張って睡眠時間を延ばしても、その質が伴わなければ、せっかくの努力が無駄になってしまうこともあります。

西川の研究機関である日本睡眠科学研究所と、同志社大学大学院生命医科学研究科/アンチエイジングリサーチセンター 米井嘉一教授との共同研究によって、睡眠時間は変えずに、睡眠の質を上げることでどれほど効果がみられるかを検証しました。結果、良質な寝具を使用して睡眠の質を改善することで、肌のうるおいやハリ、キメの数値が改善しました。
(Glycative Stress Research 7(1): 75-87, 2020.)
また、睡眠の質は腸内環境にも影響します。日本睡眠科学研究所と、同志社大学大学院生命医科学研究科/アンチエイジングリサーチセンター 米井嘉一教授との共同研究では、睡眠の質を上げることで、腸内の通称"ヤセ菌"の割合が増えることが分かりました(Glycative Stress Research 8 (2): 73-86,2021)。「ヤセ菌」は肥満の予防や改善、免疫力アップなど、健康と美容にとって嬉しい働きをしてくれます。
ピローケースの衛生的な使用について
1週間洗わずに使うと菌の繁殖は1日使用の約2.5倍に!
ピロ―ケースを洗わずに使い続けると菌が繁殖するため、洗濯習慣を持つことや、洗濯しやすい構造や抗菌加工のピロ―ケースの使用が望ましいです。西川がピローケースの菌の繁殖について検査した結果、洗わずに7日間連続使用したピローケースの菌数は、1日使用時に比べて約2.5倍に増えることがわかりました(※6)。
※6 未使用のピロ―ケースを指定日数使用したのち菌を採取。混釈平板培養法により生菌数を算出。対象者:40代男女7名。西川株式会社調べ。
〈 一般のお客様からの商品に関するお問合せ先 〉
西川株式会社
☎ 0120-36-8161 (受付時間:平日10:00〜17:00)
このプレスリリースには、メディア関係者向けの情報があります
メディアユーザー登録を行うと、企業担当者の連絡先や、イベント・記者会見の情報など様々な特記情報を閲覧できます。※内容はプレスリリースにより異なります。
すべての画像
